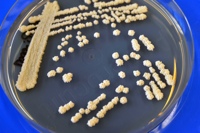

FINE AND BULK CHEMICALS
Microorganisms are the cellular factories of the future for fine chemicals and bulk chemicals. Many of these compounds cannot be efficiently produced today, or are based on fossil fuels presenting ecological or economical limitations. Sugar and other biomass-based raw materials are being used as best alternatives for the production of high quality chemicals.
We use our longstanding experience in the field of metabolic engineering for the establishment of new yeast production systems for proteins and chemicals.
We enable
- microbial production of carboxylic acids, terpenoids and other lipid substances based on our platform technologies and patent-protected strains
- development of novel production strains using classical genetics and mutagenesis, "smart breeding", and molecular biology approaches
- global expression analysis and analysis of metabolites as a basis for iterative optimization cycles
Please contact us for more information: [email protected]